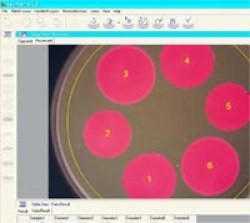

Colony Counter에 대한 궁금증을 해결해 드립니다.
IUL Colony Counter 종류
Automated Colony Counter - SphereFlash®
Haloes PRO Software
Manual Colony Counter - DOT
Q&A
질문: Sphere Flash 콜로니 카운터가 결과를 저장하는 형식은 무엇입니까?
답변: Sphere Flash 콜로니 카운터의 소프트웨어는 엑셀, CSV, XML 타입으로 데이터 저장이 가능합니다. 각 결과 테이블은 별도로 저장되며, 사용자가 이름을 지정하고 카탈로그화하여 선택한 디렉토리에서 인쇄하거나 저장할 수 있습니다.
질문: Sphere Flash 콜로니 카운터가 측정할 수 있는 가장 작은 콜로니 사이즈는 무엇인가요?
답변: Sphere Flash 자동 콜로니 카운터 고해상도 카메라(USB 3.0 DIGITAL)은 0.07mm의 작은 콜로니를 측정할 수 있습니다.
질문: Sphere Flash 콜로니 카운터로 나선형 플레이트도 측정할 수 있습니까?
답변: 예, Sphere Flash를 사용해서 나선형 플레이트를 측정할 수 있습니다.
먼저 사전 설정된 테이블에서 “rings”를 선택합니다. 그러면 외부 "rings"에 있는 콜로니가 자동으로 측정됩니다. 결과가 필요한 최소 수(보통 25개)보다 작으면 다음 "rings"도 측정됩니다. 센터를 향해 "rings"를 계산하는 이 과정은 최소 수를 초과할 때까지 계속됩니다. 그런 다음 Sphere Flash는 주어진 모든 정보를 취합해서 사용자에게 결과값을 보여줍니다.
질문: Sphere Flash의 추출 데이터를 사용자가 별도로 지정할 수 있습니까?
답변: Sphere Flash 소프트웨어를 사용해서 결과데이터를 사용자화 할 수 있습니다. 주석을 입력하고 결과와 함께 표시할 수 있으며, 모든 다른 매개 변수를 표시할 수 있으며 저장 위치를 선택할 수 있습니다.
질문: Sphere Flash 플레이트의 모든 것을 계산할 수 있습니까?
답변: 예, Sphere Flash는 육안으로 볼 수 있는 모든 것을 계산할 수 있습니다. 곰팡이 군락과 같은 구형이 아닌 콜로니는 측정이 안 될 가능성도 있습니다.
질문: Sphere Flash 콜로니 카운터를 실험실 LIMS 시스템에 연결할 수 있습니까?
답변: Sphere Flash는 사용자가 지정한 폴더에 결과 파일을 저장합니다. 파일(CSV 또는 XML)은 모든 LIM 시스템과 호환되며 결과값은 apporpiate 필드에 불러와집니다.
질문: Zone Sizing에 Sphere Flash 콜로니 카운터를 사용할 수 있습니까?
답변: Sphere Flash는 항생제 억제 실험에 사용될 수 있습니다. "Haloes PRO 소프트웨어"는 기본 Sphere Flash 소프트웨어 및 하드웨어 버전으로 구매할 수 있으며 플레이트당 최대 6개의 영역을 감지하고 직경을 계산할 수 있습니다. 소프트웨어에서 Zone Number 1 을 설정하면, 억제존의 직경을 측정하여 기록합니다.
질문: Sphere Flash가 콜로니를 측정하는데 소요되는 시간은 얼마일까요?
답변: Sphere Flash는 플레이트당 측정하는 데 약 5초가 걸립니다.
여기에는 플레이트를 열고, 플레이트를 장치 안팎으로 이동하는 것이 포함됩니다.
질문: Sphere Flash 콜로니 카운터와 컴퓨터를 연결할 수 있습니까?
답변: Sphere Flash 소프트웨어는 PC 또는 노트북에 설치할 수 있습니다 (USB 3.0 이상).
질문: Sphere Flash 는 어떤 규정을 준수해서 제작되었나요?
답변: Sphere Flash® Colonies Pro Software는 CFR 21 Part 11 규정을 준수해서 제작되었습니다.
질문: Sphere Flash 콜로니 카운터의 Calibration 방법을 알려주세요.
답변: 장비를 구매하시면, 캘리브레이션 프로토콜과 함께 보정할 수 있는 플레이트를 함께 제공해 드립니다.
질문: Sphere Flash 콜로니 카운터에 대한 기술 서비스를 지원받을 수 있습니까?
답변: 레보딕스 는 IUL의 한국 공식 대리점으로서 Sphere Flash를 구매하시는 모든 고객은
레보딕스 기술지원팀의의 IQ, OQ, PQ 밸리데이션 및 장비의 유지보수를 지원받으실 수 있습니다.
저희 레보딕스에서는 콜로니카운터 외에도 실험에서 필수적으로 사용되는 우수한 성능의 다양한 실험장비들을 취급하고 있으니 문의사항 있으신 경우 아래 연락처 혹은 레보딕스 카카오톡으로 연락주시면 더욱 자세한 상담으로 도와드리겠습니다. 감사합니다:)